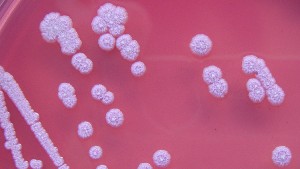
56976171c4618870568b45b7

Un estudio llevado a cabo por científicos de la Universidad de Oxford y publicado en la revista ‘Nature Microbiology’, advierte que la infección de melioidosis, resistente a muchos antibióticos, podría expandirse por todo el mundo.
Un estudio llevado a cabo por científicos de la Universidad de Oxford y publicado en la revista ‘Nature Microbiology’, advierte que la infección de melioidosis, resistente a muchos antibióticos, podría expandirse por todo el mundo.
Los investigadores presuponen que la enfermedad está presente en 79 países, incluyendo 34 que nunca han documentado la enfermedad. Según precisa el estudio, la bacteria Burkholderia pseudomallei, causante de la infección, se halla comúnmente en suelos del sur y sudeste de Asia y del norte de Australia, aunque también puede propagarse a áreas no endémicas a través de la importación de animales infectados.
Los científicos estiman que de los 165.000 casos de melioidosis registrados cada año 89.000 pueden ser mortales. Estas cifras son similares a las del sarampión o las del dengue, dos de las prioridades actuales para muchas organizaciones internacionales de salud.
Los pacientes más expuestos a la melioidosis son los que tienen diabetes mellitus, enfermedad renal crónica o los que consumen mucho alcohol.






















